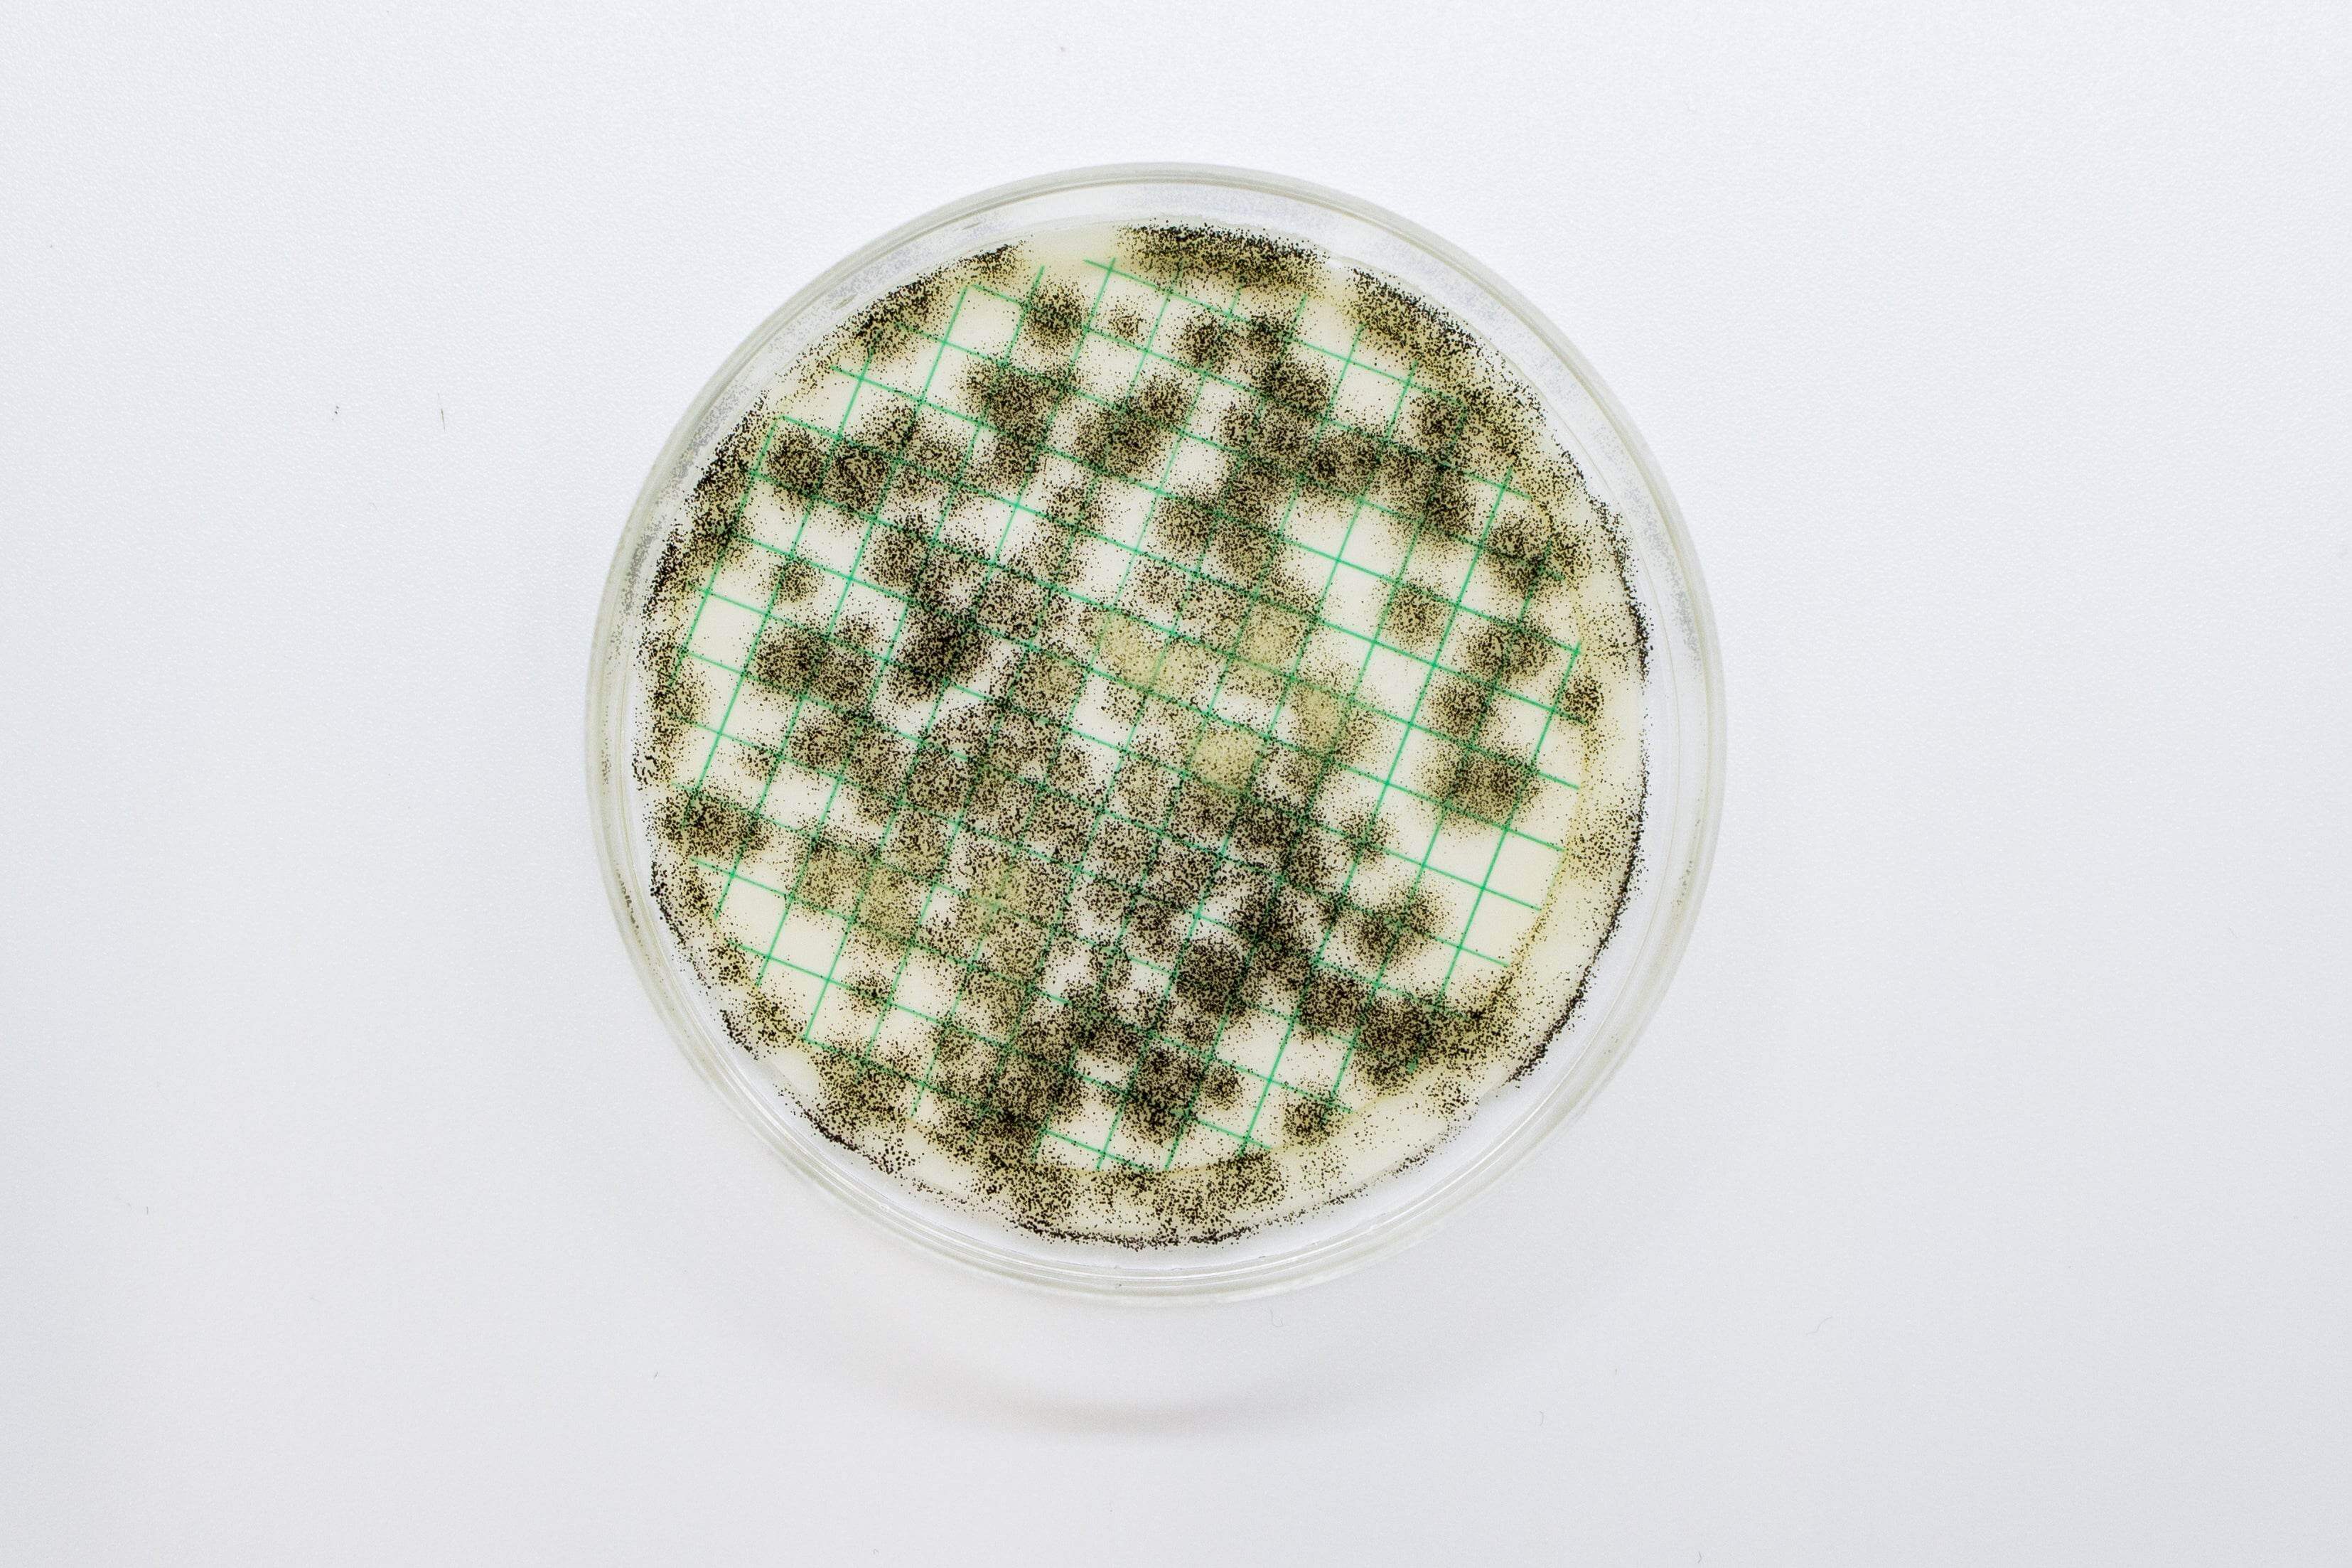
Easy Dry Orange Serum - Kormay Biomedicals store

All Products
Showing 1201 - 1224 of 1448 products
Display
View
Liofilchem
Contact Slide PCA+TTC+NEUTR/D.R.B.C+NEUTR. - For Microbiology Lab Testing
Sale price$778.00 CAD


Liofilchem
Contact Slide TSA + NEUTR./ TSA + NEUTR. - For Microbiology Lab Testing
Sale price$145.00 CAD
Filters (0)